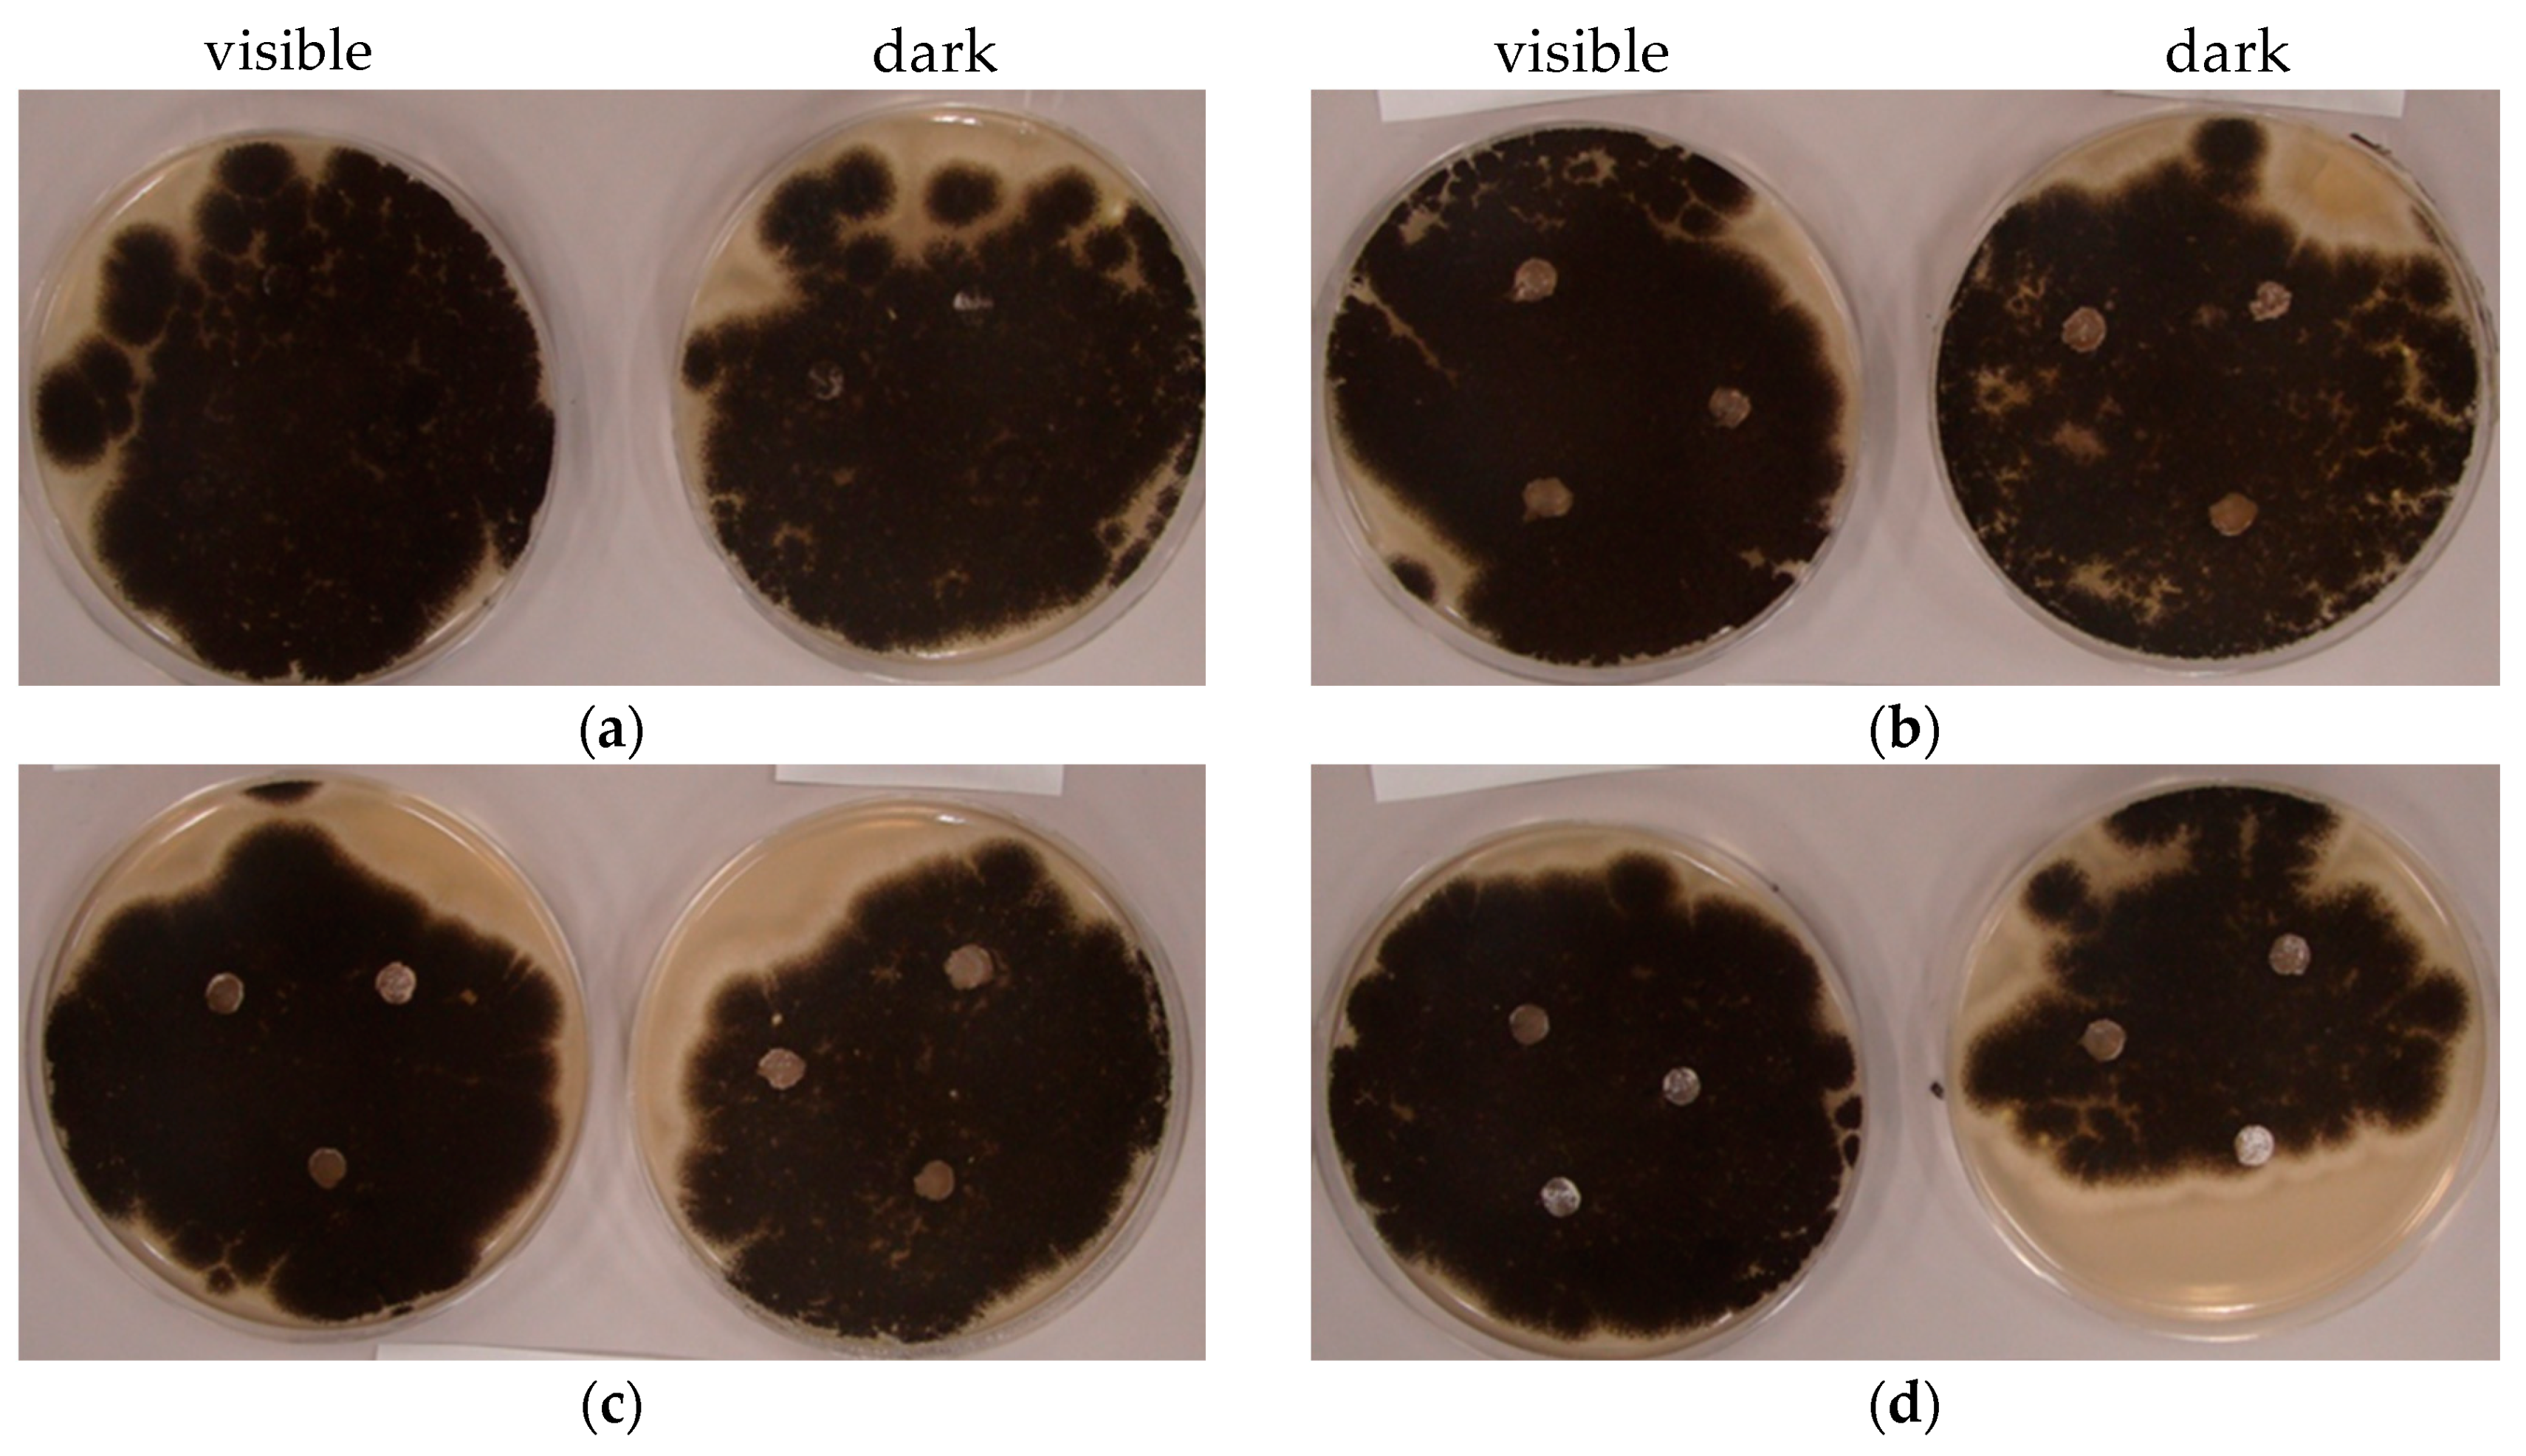
Catalysts 10 01194 g007 Catalysts 10 01194 g007

Vis-Responsive Copper-Modified Titania for Decomposition of Organic Compounds and Microorganisms
Abstract
1. Introduction
2. Results and Discussion
2.1. Preparation of Cu-Modified Titania
2.2. Photoabsorption Properties (Ultraviolet-Visible (UV-Vis) Diffuse Reflectance Spectroscopy)
2.3. X-Ray Diffraction
2.4. Scanning Electron Microscopy
2.5. X-Ray Photoelectron Spectroscopy
2.6. Photocatalytic Activity
2.7. Antibacterial Activity
2.8. Antifungal Activity
3. Materials and Methods
3.1. Preparation of Cu-Modified Titania
3.2. Characterization
3.3. Photocatalytic Activity Tests
3.4. Bactericidal Tests
3.5. Antifungal Tests
3.5.1. Disc Diffusion Test
3.5.2. Spore-Counting Test
4. Conclusions
Author Contributions
Funding
Conflicts of Interest
References
- Hoffmann, M.R.; Martin, S.T.; Choi, W.; Bahnemann, D.W. Environmental applications of photocatalysis. Chem. Rev. 1995, 95, 69–96. [Google Scholar] [CrossRef]
- Wang, Y.; Huang, Y.; Ho, W.; Zhang, L.; Zou, Z.; Lee, S. Biomolecule-controlled hydrothermal synthesis of C-N-S-tridoped TiO2 nanocrystalline photocatalysts for NO removal under simulated solar light irradiation. J. Hazard. Mater. 2009, 169, 77–87. [Google Scholar] [CrossRef] [PubMed]
- Su, C.; Tseng, C.M.; Chen, L.F.; You, B.H.; Hsu, B.C.; Chen, S.S. Sol-hydrothermal preparation and photocatalysis of titanium dioxide. Thin Solid Films 2006, 498, 259–265. [Google Scholar] [CrossRef]
- Martin, S.T.; Lee, A.T.; Hoffmann, M.R. Chemical mechanism of inorganic oxidants in the TiO2/UV process: Increased rates of degradation of chlorinated hydrocarbons. Environ. Sci. Technol. 1995, 29, 2567–2573. [Google Scholar] [CrossRef]
- Verbruggen, S.W. TiO2 photocatalysis for the degradation of pollutants in gas phase: From morphological design to plasmonic enhancement. J. Photochem. Photobiol. C Photochem. Rev. 2015, 24, 64–82. [Google Scholar] [CrossRef]
- Fujishima, A.; Honda, K. Electrochemical photolysis of water at a semiconductor electrode. Nature 1972, 238, 37–38. [Google Scholar] [CrossRef]
- Fujishima, A.; Rao, T.N.; Tryk, D.A. Titanium dioxide photocatalysis. J. Photochem. Photobiol. C Photochem. Rev. 2000, 1, 1–21. [Google Scholar] [CrossRef]
- Byrne, C.; Subramanian, G.; Pillai, S.C. Recent advances in photocatalysis for environmental applications. J. Environ. Chem. Eng. 2018, 6, 3531–3555. [Google Scholar] [CrossRef]
- Ohtani, B.; Prieto-Mahaney, O.O.; Li, D.; Abe, R. What is degussa (Evonic) P25? Crystalline composition analysis, reconstruction from isolated pure particles and photocatalytic activity test. J. Photochem. Photobiol. A Chem. 2010, 216, 179–182. [Google Scholar] [CrossRef]
- Crampton, A.S.; Cai, L.; Janvelyan, N.; Zheng, X.; Friend, C.M. Methanol photo-oxidation on rutile TiO2 nanowires: Probing reaction pathways on complex materials. J. Phys. Chem. C 2017, 121, 9910–9919. [Google Scholar] [CrossRef]
- Liu, Y.; Chen, L.; Hu, J.; Li, J.; Richards, R. TiO2 nanoflakes modified with gold nanoparticles as photocatalysts with high activity and durability under near UV irradiation. J. Phys. Chem. C 2010, 114, 1641–1645. [Google Scholar] [CrossRef]
- Anitha, V.C.; Hamnabard, N.; Banerjee, A.N.; Dillip, G.R.; Joo, S.W. Enhanced electrochemical performance of morphology-controlled titania-reduced graphene oxide nanostructures fabricated via a combined anodization-hydrothermal process. RSC Adv. 2016, 6, 12571–12583. [Google Scholar] [CrossRef]
- Huang, X.; Meng, L.; Du, M.; Li, Y. TiO2 nanorods: Hydrothermal fabrication and photocatalytic activities. J. Mater. Sci. Mater. Electron. 2016, 27, 7222–7226. [Google Scholar] [CrossRef]
- Bian, Z.; Tachikawa, T.; Zhang, P.; Fujitsuka, M.; Majima, T. Au/TiO2 superstructure-based plasmonic photocatalysts exhibiting efficient charge separation and unprecedented activity. J. Am. Chem. Soc. 2014, 136, 458–465. [Google Scholar] [CrossRef] [PubMed]
- Abbas, W.A.; Ramadan, M.; Faid, A.Y.; Abdellah, A.M.; Ouf, A.; Moustafa, N.; Allam, N.K. Photoactive catalysts for effective water microbial purification: Morphology-activity relationship. Environ. Nanotechnol. Monit. Manag. 2018, 10, 87–93. [Google Scholar] [CrossRef]
- Stafford, U.; Gray, K.A.; Kamat, P.V.; Varma, A. An in situ diffuse reflectance FTIR investigation of photocatalytic degradation of 4-chlorophenol on a TiO2 powder surface. Chem. Phys. Lett. 1993, 205, 55–61. [Google Scholar] [CrossRef]
- Smirnova, N.; Fesenko, T.; Zhukovsky, M.; Goworek, J.; Eremenko, A. Photodegradation of stearic acid adsorbed on superhydrophilic TiO2 surface: In situ FT-IR and LDI study. Nanoscale Res. Lett. 2015, 10, 1–7. [Google Scholar] [CrossRef]
- Mamaghani, A.H.; Haghighat, F.; Lee, C.S. Role of titanium dioxide (TiO2) structural design/morphology in photocatalytic air purification. Appl. Catal. B Environ. 2020, 269, 118735. [Google Scholar] [CrossRef]
- Ghosh, M.; Lohrasbi, M.; Chuang, S.S.C.; Jana, S.C. Mesoporous titanium dioxide nanofibers with a significantly enhanced photocatalytic activity. ChemCatChem 2016, 8, 2525–2535. [Google Scholar] [CrossRef]
- Al-Mamun, M.R.; Kader, S.; Islam, M.S.; Khan, M.Z.H. Photocatalytic activity improvement and application of UV-TiO2 photocatalysis in textile wastewater treatment: A review. J. Environ. Chem. Eng. 2019, 7, 103248. [Google Scholar] [CrossRef]
- Ohtani, B. Preparing articles on photocatalysis—Beyond the illusions, misconceptions, and speculation. Chem. Lett. 2008, 37, 217–229. [Google Scholar] [CrossRef]
- Anpo, M.; Takeuchi, M. The design and development of highly reactive titanium oxide photocatalysts operating under visible light irradiation. J. Catal. 2003, 216, 505–516. [Google Scholar] [CrossRef]
- Karvinen, S.; Hirva, P.; Pakkanen, T.A. Ab initio quantum chemical studies of cluster models for doped anatase and rutile TiO2. J. Mol. Struct. Theochem. 2003, 626, 271–277. [Google Scholar] [CrossRef]
- Zhu, J.; Deng, Z.; Chen, F.; Zhang, J.; Chen, H.; Anpo, M.; Huang, J.; Zhang, L. Hydrothermal doping method for preparation of Cr3+-TiO2 photocatalysts with concentration gradient distribution of Cr3+. Appl. Catal. B Environ. 2006, 62, 329–335. [Google Scholar] [CrossRef]
- Tada, H.; Mitsui, T.; Kiyonaga, T.; Akita, T.; Tanaka, K. All-solid-state Z-scheme in CdS-Au-TiO2 three-component nanojunction system. Nat. Mater. 2006, 5, 782–786. [Google Scholar] [CrossRef]
- Ghosh, M.; Liu, J.; Chuang, S.S.C.; Jana, S.C. Fabrication of hierarchical V2O5 nanorods on TiO2 nanofibers and their enhanced photocatalytic activity under visible light. ChemCatChem 2018, 10, 3305–3318. [Google Scholar] [CrossRef]
- Yang, J.; Zhang, J.; Zou, B.; Zhang, H.; Wang, J.; Schubert, U.; Rui, Y. Black SnO2-TiO2 Nanocomposites with high dispersion for photocatalytic and photovoltalic applications. ACS Appl. Nano Mater. 2020, 3, 4265–4273. [Google Scholar] [CrossRef]
- Zhang, L.; Yu, W.; Han, C.; Guo, J.; Zhang, Q.; Xie, H.; Shao, Q.; Sun, Z.; Guo, Z. Large scaled synthesis of heterostructured electrospun TiO2/SnO2 nanofibers with an enhanced photocatalytic activity. J. Electrochem. Soc. 2017, 164, H651–H656. [Google Scholar] [CrossRef]
- Li, J.J.; Weng, B.; Cai, S.C.; Chen, J.; Jia, H.P.; Xu, Y.J. Efficient promotion of charge transfer and separation in hydrogenated TiO2/WO3 with rich surface-oxygen-vacancies for photodecomposition of gaseous toluene. J. Hazard. Mater. 2018, 342, 661–669. [Google Scholar] [CrossRef]
- Chen, X.; Liu, L.; Yu, P.Y.; Mao, S.S. Increasing solar absorption for photocatalysis with black hydrogenated titanium dioxide nanocrystals. Science 2011, 331, 746–750. [Google Scholar] [CrossRef]
- Kraeutler, B.; Bard, A.J. Heterogeneous photocatalytic preparation of supported catalysts. Photodeposition of platinum on TiO2 powder and other substrates. J. Am. Chem. Soc. 1978, 100, 4317–4318. [Google Scholar] [CrossRef]
- Sclafani, A.; Mozzanega, M.-N.; Pichat, P. Effect of silver deposits on the photocatalytic activity of titanium dioxide samples for the dehydrogenation or oxidation of 2-propanol. J. Photochem. Photobiol. A Chem. 1991, 59, 181–189. [Google Scholar] [CrossRef]
- Disdier, J.; Herrmann, J.-M.; Pichat, P. Platinum/titanium dioxide catalysts. J. Chem. Soc. Faraday Trans. 1983, 79, 651–660. [Google Scholar] [CrossRef]
- Kamat, P.V. Photochemistry on nonreactive and reactive (semiconductor) surfaces. Chem. Rev. 1993, 93, 267–300. [Google Scholar] [CrossRef]
- Wang, C.Y.; Bahnemann, D.W.; Dohrmann, J.K. A novel preparation of iron-doped TiO2 nanoparticles with enhanced photocatalytic activity. Chem. Commun. 2000, 1539–1540. [Google Scholar] [CrossRef]
- Zakeeruddin, S.M.; Nazeeruddin, M.K.; Humphry-Baker, R.; Péchy, P.; Quagliotto, P.; Barolo, C.; Viscardi, G.; Grätzel, M. Design, synthesis, and application of amphiphilic ruthenium polypyridyl photosensitizers in solar cells based on nanocrystalline TiO2 films. Langmuir 2002, 18, 952–954. [Google Scholar] [CrossRef]
- Bae, E.; Choi, W. Effect of the anchoring group (carboxylate vs phosphonate) in Ru-complex-sensitized TiO2 on hydrogen production under visible light. J. Phys. Chem. B 2006, 110, 14792–14799. [Google Scholar] [CrossRef]
- Park, H.; Choi, W. Effects of TiO2 surface fluorination on photocatalytic reactions and photoelectrochemical behaviors. J. Phys. Chem. B 2004, 108, 4086–4093. [Google Scholar] [CrossRef]
- Di Paola, A.; Marcì, G.; Palmisano, L.; Schiavello, M.; Uosaki, K.; Ikeda, S.; Ohtani, B. Preparation of polycrystalline TiO2 photocatalysts impregnated with various transition metal ions: Characterization and photocatalytic activity for the degradation of 4-nitrophenol. J. Phys. Chem. B 2002, 106, 637–645. [Google Scholar] [CrossRef]
- Reszczyńska, J.; Grzyb, T.; Wei, Z.; Klein, M.; Kowalska, E.; Ohtani, B.; Zaleska-Medynska, A. Photocatalytic activity and luminescence properties of RE3+-TiO2 nanocrystals prepared by sol-gel and hydrothermal methods. Appl. Catal. B Environ. 2016, 181, 825–837. [Google Scholar] [CrossRef]
- Kusiak-Nejman, E.; Janus, M.; Grzmil, B.; Morawski, A.W. Methylene Blue decomposition under visible light irradiation in the presence of carbon-modified TiO2 photocatalysts. J. Photochem. Photobiol. A Chem. 2011, 226, 68–72. [Google Scholar] [CrossRef]
- Markowska-Szczupak, A.; Rokicka, P.; Wang, K.; Endo, M.; Morawski, A.; Kowalska, E. Photocatalytic water disinfection under solar irradiation by d-glucose-modified titania. Catalysts 2018, 8, 316. [Google Scholar] [CrossRef]
- Wang, K.; Endo-Kimura, M.; Belchi, R.; Zhang, D.; Habert, A.; Bouclé, J.; Ohtani, B.; Kowalska, E.; Herlin-Boime, N. Carbon/graphene-modified titania with enhanced photocatalytic activity under UV and vis irradiation. Materials 2019, 12, 4158. [Google Scholar] [CrossRef] [PubMed]
- Kowalska, E.; Mahaney, O.O.P.; Abe, R.; Ohtani, B. Visible-light-induced photocatalysis through surface plasmon excitation of gold on titania surfaces. Phys. Chem. Chem. Phys. 2010, 12, 2344–2355. [Google Scholar] [CrossRef]
- Linic, S.; Christopher, P.; Ingram, D.B. Plasmonic-metal nanostructures for efficient conversion of solar to chemical energy. Nat. Mater. 2011, 10, 911–921. [Google Scholar] [CrossRef]
- Tian, Y.; Tatsuma, T. Mechanisms and applications of plasmon-induced charge separation at TiO2 films loaded with gold nanoparticles. J. Am. Chem. Soc. 2005, 127, 7632–7637. [Google Scholar] [CrossRef]
- Raja-Mogan, T.; Ohtani, B.; Kowalska, E. Photonic crystals for plasmonic photocatalysis. Catalysts 2020, 10, 827. [Google Scholar] [CrossRef]
- Rycenga, M.; Cobley, C.M.; Zeng, J.; Li, W.; Moran, C.H.; Zhang, Q.; Qin, D.; Xia, Y. Controlling the synthesis and assembly of silver nanostructures for plasmonic applications. Chem. Rev. 2011, 111, 3669–3712. [Google Scholar] [CrossRef]
- Kazuma, E.; Yamaguchi, T.; Sakai, N.; Tatsuma, T. Growth behaviour and plasmon resonance properties of photocatalytically deposited Cu nanoparticles. Nanoscale 2011, 3, 3641–3645. [Google Scholar] [CrossRef]
- El-sayed, M.A. Some interesting properties of metals confined in time and nanometer space of different shapes. Acc. Chem. Res. 2001, 34, 257–264. [Google Scholar] [CrossRef]
- Burda, C.; Chen, X.; Narayanan, R.; El-Sayed, M.A. Chemistry and properties of nanocrystals of different shapes. Chem. Rev. 2005, 105, 1025–1102. [Google Scholar] [CrossRef] [PubMed]
- Brus, L. Noble metal nanocrystals: Plasmon electron transfer photochemistry and single molecule raman spectroscopy. Acc. Chem. Res. 2008, 41, 1742–1749. [Google Scholar] [CrossRef] [PubMed]
- Xia, Y.; Xiong, Y.; Lim, B.; Skrabalak, S.E. Shape-controlled synthesis of metal nanocrystals: Simple chemistry meets complex physics? Angew. Chem. Int. Ed. 2009, 48, 60–103. [Google Scholar] [CrossRef]
- Kelly, K.L.; Coronado, E.; Zhao, L.L.; Schatz, G.C. The optical properties of metal nanoparticles: The influence of size, shape, and dielectric environment. J. Phys. Chem. B 2003, 107, 668–677. [Google Scholar] [CrossRef]
- Hou, W.; Cronin, S.B. A review of surface plasmon resonance-enhanced photocatalysis. Adv. Funct. Mater. 2013, 23, 1612–1619. [Google Scholar] [CrossRef]
- Evanoff, D.D.; Chumanov, G. Synthesis and optical properties of silver nanoparticles and arrays. ChemPhysChem 2005, 6, 1221–1231. [Google Scholar] [CrossRef]
- Jain, P.K.; Huang, X.; El-Sayed, I.H.; El-Sayed, M.A. Noble metals on the nanoscale: Optical and photothermal properties and some applications in imaging, sensing, biology, and medicine. Acc. Chem. Res. 2008, 41, 1578–1586. [Google Scholar] [CrossRef]
- Matsunaga, T.; Tomoda, R.; Nakajima, T.; Wake, H. Photoelectrochemical sterilization of microbial cells by semiconductor powders. FEMS Microbiol. Lett. 1985, 29, 211–214. [Google Scholar] [CrossRef]
- Wolfrum, E.J.; Huang, J.; Blake, D.M.; Maness, P.C.; Huang, Z.; Fiest, J.; Jacoby, W.A. Photocatalytic oxidation of bacteria, bacterial and fungal spores, and model biofilm components to carbon dioxide on titanium dioxide-coated surfaces. Environ. Sci. Technol. 2002, 36, 3412–3419. [Google Scholar] [CrossRef]
- Armon, R.; Weitch-Cohen, G.; Bettane, P. Disinfection of Bacillus spp. spores in drinking water by TiO2 photocatalysis as a model for Bacillus anthracis. Water Sci. Technol. Water Supply 2004, 4, 7–14. [Google Scholar] [CrossRef]
- Dillert, R.; Siemon, U.; Bahnemann, D. Photocatalytic disinfection of municipal wastewater. Chem. Eng. Technol. 1998, 21, 356–358. [Google Scholar] [CrossRef]
- Wei, C.; Lin, W.Y.; Zainal, Z.; Williams, N.E.; Zhu, K.; Kruzlc, A.P.; Smith, R.L.; Rajeshwar, K. Bactericidal activity of TiO2 photocatalyst in aqueous media: Toward a solar-assisted water disinfection system. Environ. Sci. Technol. 1994, 28, 934–938. [Google Scholar] [CrossRef] [PubMed]
- Kim, B.; Kim, D.; Cho, D.; Cho, S. Bactericidal effect of TiO2 photocatalyst on selected food-borne pathogenic bacteria. Chemosphere 2003, 52, 277–281. [Google Scholar] [CrossRef]
- Wu, P.; Xie, R.; Imlay, K.; Shang, J.K. Monolithic ceramic foams for ultrafast photocatalytic inactivation of bacteria. J. Am. Ceram. Soc. 2009, 92, 1648–1654. [Google Scholar] [CrossRef]
- Keller, V.; Keller, N.; Ledoux, M.J.; Lett, M.C. Biological agent inactivation in a flowing air stream by photocatalysis. Chem. Commun. 2005, 2918–2920. [Google Scholar] [CrossRef]
- Porley, V.; Chatzisymeon, E.; Meikap, B.C.; Ghosal, S.; Robertson, N. Field testing of low-cost titania-based photocatalysts for enhanced solar disinfection (SODIS) in rural India. Environ. Sci. Water Res. Technol. 2020, 6, 809–816. [Google Scholar] [CrossRef]
- Hockberger, P.E. A History of ultraviolet photobiology for humans, animals and microorganisms. Photochem. Photobiol. 2002, 76, 561. [Google Scholar] [CrossRef]
- Markowska-Szczupak, A.; Ulfig, K.; Morawski, A.W. The application of titanium dioxide for deactivation of bioparticulates: An overview. Catal. Today 2011, 169, 249–257. [Google Scholar] [CrossRef]
- Sunada, K.; Minoshima, M.; Hashimoto, K. Highly efficient antiviral and antibacterial activities of solid-state cuprous compounds. J. Hazard. Mater. 2012, 235, 265–270. [Google Scholar] [CrossRef]
- Deng, C.H.; Gong, J.L.; Zeng, G.M.; Zhang, P.; Song, B.; Zhang, X.G.; Liu, H.Y.; Huan, S.Y. Graphene sponge decorated with copper nanoparticles as a novel bactericidal filter for inactivation of Escherichia coli. Chemosphere 2017, 184, 347–357. [Google Scholar] [CrossRef]
- Jafari, A.; Pourakbar, L.; Farhadi, K.; Mohamadgolizad, L.; Goosta, Y. Biological synthesis of silver nanoparticles and evaluation of antibacterial and antifungal properties of silver and copper nanoparticles. Turkish J. Biol. 2015, 39, 556–561. [Google Scholar] [CrossRef]
- Qiu, X.; Miyauchi, M.; Sunada, K.; Minoshima, M.; Liu, M.; Lu, Y.; Li, D.; Shimodaira, Y.; Hosogi, Y.; Kuroda, Y.; et al. Hybrid CuxO/TiO2 nanocomposites as risk-reduction materials in indoor environments. ACS Nano 2012, 6, 1609–1618. [Google Scholar] [CrossRef] [PubMed]
- Endo, M.; Janczarek, M.; Wei, Z.; Wang, K.; Markowska-Szczupak, A.; Ohtani, B.; Kowalska, E. Bactericidal properties of plasmonic photocatalysts composed of noble metal nanoparticles on faceted anatase titania. J. Nanosci. Nanotechnol. 2019, 19, 442–452. [Google Scholar] [CrossRef] [PubMed]
- Ohtani, B.; Mahaney, O.O.P.; Amano, F.; Murakami, N.; Abe, R. What are titania photocatalysts?-An exploratory correlation of photocatalytic activity with structural and physical properties. J. Adv. Oxid. Technol. 2010, 13, 247–261. [Google Scholar] [CrossRef]
- Nitta, A.; Takashima, M.; Takase, M.; Ohtani, B. Identification and characterization of titania photocatalyst powders using their energy-resolved distribution of electron traps as a fingerprint. Catal. Today 2019, 321, 2–8. [Google Scholar] [CrossRef]
- Kowalska, E.; Wei, Z.; Karabiyik, B.; Herissan, A.; Janczarek, M.; Endo, M.; Markowska-Szczupak, A.; Remita, H.; Ohtani, B. Silver-modified titania with enhanced photocatalytic and antimicrobial properties under UV and visible light irradiation. Catal. Today 2015, 252, 136–142. [Google Scholar] [CrossRef]
- Prieto-Mahaney, O.-O.; Murakami, N.; Abe, R.; Ohtani, B. Correlation between photocatalytic activities and structural and physical properties of titanium(IV) oxide powders. Chem. Lett. 2009, 38, 238–239. [Google Scholar] [CrossRef]
- Kakuma, Y.; Nosaka, A.Y.; Nosaka, Y. Difference in TiO2 photocatalytic mechanism between rutile and anatase studied by the detection of active oxygen and surface species in water. Phys. Chem. Chem. Phys. 2015, 17, 18691–18698. [Google Scholar] [CrossRef]
- Buchalska, M.; Kobielusz, M.; Matuszek, A.; Pacia, M.; Wojtyła, S.; Macyk, W. On oxygen activation at rutile-and anatase-TiO2. ACS Catal. 2015, 5, 7424–7431. [Google Scholar] [CrossRef]
- Min, B.K.; Wallace, W.T.; Goodman, D.W. Support effects on the nucleation, growth, and morphology of gold nano-clusters. Surf. Sci. 2006, 600, L7–L11. [Google Scholar] [CrossRef]
- Janczarek, M.; Wei, Z.; Endo, M.; Ohtani, B.; Kowalska, E. Silver- and copper-modified decahedral anatase titania particles as visible light-responsive plasmonic photocatalyst. J. Photonics Energy 2017, 7, 012008. [Google Scholar] [CrossRef]
- DeSario, P.A.; Pietron, J.J.; Brintlinger, T.H.; McEntee, M.; Parker, J.F.; Baturina, O.; Stroud, R.M.; Rolison, D.R. Oxidation-stable plasmonic copper nanoparticles in photocatalytic TiO2 nanoarchitectures. Nanoscale 2017, 9, 11720–11729. [Google Scholar] [CrossRef] [PubMed]
- Wei, Z.; Janczarek, M.; Endo, M.; Wang, K.; Balčytis, A.; Nitta, A.; Méndez-medrano, M.G.; Colbeau-justin, C.; Juodkazis, S.; Ohtani, B.; et al. Noble metal-modified faceted anatase titania photocatalysts: Octahedron versus decahedron. Appl. Catal. B Environ. 2018, 237, 574–587. [Google Scholar] [CrossRef]
- Banerjee, S.; Chakravorty, D. Optical absorption by nanoparticles of Cu2O. Europhys. Lett. 2000, 52, 468–473. [Google Scholar] [CrossRef]
- Dias Filho, N.L. Adsorption of Cu(II) and Co(II) complexes on a silica gel surface chemically modified with 2-mercaptoimidazole. Mikrochim. Acta 1999, 130, 233–240. [Google Scholar] [CrossRef]
- Irie, H.; Kamiya, K.; Shibanuma, T.; Miura, S.; Tryk, D.A.; Yokoyama, T.; Hashimoto, K. Visible light-sensitive Cu(II)-grafted TiO2 photocatalysts: Activities and X-ray absorption fine structure analyses. J. Phys. Chem. C 2009, 113, 10761–10766. [Google Scholar] [CrossRef]
- Janczarek, M.; Endo, M.; Zhang, D.; Wang, K.; Kowalska, E. Enhanced photocatalytic and antimicrobial performance of cuprous oxide/titania: The effect of titania matrix. Materials 2018, 11, 2069. [Google Scholar] [CrossRef]
- Endo-Kimura, M.; Janczarek, M.; Bielan, Z.; Zhang, D.; Wang, K.; Markowska-Szczupak, A.; Kowalska, E. Photocatalytic and antimicrobial properties of Ag2O/TiO2 heterojunction. ChemEngineering 2019, 3, 3. [Google Scholar] [CrossRef]
- Ikeda, S.; Sugiyama, N.; Pal, B.; Marcí, G.; Palmisano, L.; Noguchi, H.; Uosaki, K.; Ohtani, B. Photocatalytic activity of transition-metal-loaded titanium(IV) oxide powders suspended in aqueous solutions: Correlation with electron-hole recombination kinetics. Phys. Chem. Chem. Phys. 2001, 3, 267–273. [Google Scholar] [CrossRef]
- Janczarek, M.; Kowalska, E. On the origin of enhanced photocatalytic activity of copper-modified titania in the oxidative reaction systems. Catalysts 2017, 7, 317. [Google Scholar] [CrossRef]
- Kowalska, E.; Abe, R.; Ohtani, B. Visible light-induced photocatalytic reaction of gold-modified titanium(IV) oxide particles: Action spectrum analysis. Chem. Commun. 2009, 241–243. [Google Scholar] [CrossRef]
- Kowalska, E.; Rau, S.; Ohtani, B. Plasmonic titania photocatalysts active under UV and visible-light irradiation: Influence of gold amount, size, and shape. J. Nanotechnol. 2012, 2012, 1–11. [Google Scholar] [CrossRef]
- Zielińska-Jurek, A.; Kowalska, E.; Sobczak, J.W.; Lisowski, W.; Ohtani, B.; Zaleska, A. Preparation and characterization of monometallic (Au) and bimetallic (Ag/Au) modified-titania photocatalysts activated by visible light. Appl. Catal. B Environ. 2011, 101, 504–514. [Google Scholar] [CrossRef]
- Wei, Z.; Rosa, L.; Wang, K.; Endo, M.; Juodkazis, S.; Ohtani, B.; Kowalska, E. Size-controlled gold nanoparticles on octahedral anatase particles as efficient plasmonic photocatalyst. Appl. Catal. B Environ. 2017, 206, 393–405. [Google Scholar] [CrossRef]
- Méndez-Medrano, M.G.; Kowalska, E.; Ohtani, B.; Bahena Uribe, D.; Colbeau-Justin, C.; Rau, S.; Rodríguez-López, J.L.; Remita, H. Heterojunction of CuO nanoclusters with TiO2 for photo-oxidation of organic compounds and for hydrogen production. J. Chem. Phys. 2020, 153, 034705. [Google Scholar] [CrossRef]
- Werapun, U.; Pechwang, J. Synthesis and Antimicrobial Activity of Fe:TiO2 Particles. J. Nano Res. 2019, 56, 28–38. [Google Scholar] [CrossRef]
- Gurr, J.; Wang, A.S.S.; Chen, C.; Jan, K. Ultrafine titanium dioxide particles in the absence of photoactivation can induce oxidative damage to human bronchial epithelial cells. Toxicology 2005, 213, 66–73. [Google Scholar] [CrossRef]
- Vargas, M.A.; Rodríguez-Páez, J.E. Facile Synthesis of TiO2 Nanoparticles of different crystalline phases and evaluation of their antibacterial effect under dark conditions against E. coli. J. Clust. Sci. 2019, 30, 379–391. [Google Scholar] [CrossRef]
- Endo-Kimura, M.; Kowalska, E. Plasmonic photocatalysts for microbiological applications. Catalysts 2020, 10, 824. [Google Scholar] [CrossRef]
- Wang, M.; Zhao, Q.; Yang, H.; Shi, D.; Qian, J. Photocatalytic antibacterial properties of copper doped TiO2 prepared by high-energy ball milling. Ceram. Int. 2020, 46, 16716–16724. [Google Scholar] [CrossRef]
- Grass, G.; Rensing, C.; Solioz, M. Metallic copper as an antimicrobial surface. Appl. Environ. Microbiol. 2011, 77, 1541–1547. [Google Scholar] [CrossRef] [PubMed]
- Mathew, S.; Ganguly, P.; Rhatigan, S.; Kumaravel, V.; Byrne, C.; Hinder, S.J.; Bartlett, J.; Nolan, M.; Pillai, S.C. Cu-Doped TiO2: Visible light assisted photocatalytic antimicrobial activity. Appl. Sci. 2018, 8, 2067. [Google Scholar] [CrossRef]
- Miró-canturri, A.; Ayerbe-algaba, R.; Smani, Y. Drug repurposing for the treatment of bacterial and fungal infections. Front. Microbiol. 2019, 10, 41. [Google Scholar]
- Markowska-Szczupak, A.; Wang, K.; Rokicka, P.; Endo, M.; Wei, Z.; Ohtani, B.; Morawski, A.W.; Kowalska, E. The effect of anatase and rutile crystallites isolated from titania P25 photocatalyst on growth of selected mould fungi. J. Photochem. Photobiol. B Biol. 2015, 151, 54–62. [Google Scholar] [CrossRef] [PubMed]
- Eisenman, H.C.; Casadevall, A. Synthesis and assembly of fungal melanin. Appl. Microbiol. Biotechnol. 2015, 93, 931–940. [Google Scholar] [CrossRef]
- Kühn, K.P.; Chaberny, I.F.; Massholder, K.; Stickler, M.; Benz, V.W.; Sonntag, H.G.; Erdinger, L. Disinfection of surfaces by photocatalytic oxidation with titanium dioxide and UVA light. Chemosphere 2003, 53, 71–77. [Google Scholar] [CrossRef]
- Endo, M.; Wei, Z.; Wang, K.; Karabiyik, B.; Yoshiiri, K.; Rokicka, P.; Ohtani, B.; Markowska-Szczupak, A.; Kowalska, E. Noble metal-modified titania with visible-light activity for the decomposition of microorganisms. Beilstein J. Nanotechnol. 2018, 9, 829–841. [Google Scholar] [CrossRef]
- Antsotegi-Uskola, M.; Markina-Iñarrairaegui, A.; Ugalde, U. New insights into copper homeostasis in filamentous fungi. Int. Microbiol. 2020, 23, 65–73. [Google Scholar] [CrossRef]
- Chen, F.; Yang, X.; Wu, Q. Antifungal capability of TiO2 coated film on moist wood. Build. Environ. 2009, 44, 1088–1093. [Google Scholar] [CrossRef]
- Markowska-Szczupak, A.; Ulfig, K.; Morawski, A.W. Antifungal effect of titanium dioxide, indoor light and the photocatalytic process in in vitro test on different media. J. Adv. Oxid. Technol. 2012, 15, 30–33. [Google Scholar] [CrossRef]
- Meletiadis, J.; Meis, J.F.G.M.; Mouton, J.W. Analysis of growth characteristics of filamentous fungi in different nutrient media. J. Clin. Microbiol. 2001, 39, 478–484. [Google Scholar] [CrossRef] [PubMed]
- Pombeiro-Sponchiado, S.R.; Sousa, G.S.; Andrade, J.C.R.; Lisboa, H.F.; Gonçalves, R.C.R. Production of melanin pigment by fungi and its biotechnological applications. In Melanin; Blumenberg, M., Ed.; InTechOpen: London, UK, 2017. [Google Scholar]
- Carlile, M.J. The Photobiology of Fungi. Annu. Rev. Plant. Physiol 1965, 16, 175–202. [Google Scholar] [CrossRef]
- Hill, E.P. Effect of light on growth and sporulation of Aspergillus ornatus. J. Gen. Microbiol 1976, 95, 39–44. [Google Scholar] [CrossRef] [PubMed]
- Kopke, K.; Hoff, B.; Bloemendal, S.; Katschorowski, A.; Kamerewerd, J.; Kück, U. Members of the Penicillium chrysogenum velvet complex play functionally opposing roles in the regulation of penicillin biosynthesis and conidiation. Eukaryot. Cell 2013, 12, 299–310. [Google Scholar] [CrossRef] [PubMed]
- Raffaini, G.; Ganazzoli, F. Molecular modelling of protein adsorption on the surface of titanium dioxide polymorphs. Philos. Trans. R. Soc. A Math. Phys. Eng. Sci. 2012, 370, 1444–1462. [Google Scholar] [CrossRef] [PubMed]
- Liu, Q.; Zhang, Y.; Laskowski, J.S. The adsorption of polysaccharides onto mineral surfaces: An acid/base interaction. Int. J. Miner. Process. 2000, 60, 229–245. [Google Scholar] [CrossRef]
- Topoglidis, E.; Cass, A.E.G.; Gilardi, G.; Sadeghi, S.; Beaumont, N.; Durrant, J.R. Protein adsorption on nanocrystalline TiO2 films: An immobilization strategy for bioanalytical devices. Anal. Chem. 1998, 70, 5111–5113. [Google Scholar] [CrossRef]
- Ellingsen, J.E. A study on the mechanism of protein adsorption to TiO2. Biomaterials 1991, 12, 593–596. [Google Scholar] [CrossRef]
- Price, M.S.; Classen, J.J.; Payne, G.A. Aspergillus niger absorbs copper and zinc from swine wastewater. Bioresour. Technol. 2001, 77, 41–49. [Google Scholar] [CrossRef]
- Markov, S.L.; Vidaković, A.M. Testing methods for antimicrobial activity of TiO2 photocatalyst. Acta Period. Technol. 2014, 45, 141–152. [Google Scholar] [CrossRef]

| Titania | Crystalline Form I (A%) II | Crystallite Size III (nm) | SSA III (m2 g−1) | ETs III (μmol g−1) |
|---|---|---|---|---|
| ST-01 | A (100) | 8 | 298 | 84 |
| FP6 | A/R (92.5) | 15 | 103.7 IV | 154 IV |
| P25 | A/R (84.8) | 28 | 59 | 50 |
| ST-41 | A/R (99.7) | 208 | 11 | 25 |
| TIO-6 | R (0) | 15 | 100 | 242 |
| ST-G1 | R/A (1.9) | 205 | 5.7 | 50 |
| TIO-5 | R/A (8.6) | 570 | 3 | 14 |
| Titania | Crystalline Content/% | Crystallite Size/nm | |||||||
|---|---|---|---|---|---|---|---|---|---|
| Anatase | Rutile | Cu | Cu2O | Anatase | Rutile | Cu | Cu2O | ||
| ST-01 | m-1h | 98.0 | 0 | 1.3 | 0.7 | 8.5 | ND | 8.6 | 8.6 |
| w-1h | 99.7 | 0 | 0.01 | 0.3 | 8.5 | ND | ND | 0.7 | |
| m-5h | 96.9 | 0 | 2.4 | 0.7 | 8.3 | ND | 1.9 | 0.7 | |
| FP6 | m-1h | 92.0 | 7.0 | 0.2 | 0.8 | 12.5 | 12.0 | 12.3 | 9.7 |
| w-1h | 90.9 | 7.0 | 1.7 | 0.5 | 12.6 | 11.1 | 11.3 | 15.6 | |
| m-5h | 93.9 | 5.8 | 0.1 | 0.2 | 12.3 | 14.7 | 9.3 | 9.2 | |
| P25 | m-1h | 81.6 | 16.7 | 0.4 | 1.4 | 23.2 | 38.8 | 2.4 | 2.9 |
| w-1h | 82.9 | 16.1 | 0.1 | 0.9 | 22.9 | 41.2 | 10.2 | 11.2 | |
| m-5h | 83.6 | 15.5 | 0.8 | 0.15 | 22.9 | 44.6 | 10.1 | 4.6 | |
| ST-41 | m-1h | 95.7 | 3.3 | 0.5 | 0.5 | 80.8 | 12.0 | 40.3 | 34.9 |
| w-1h | 98.3 | 0.9 | 0.4 | 0.4 | 78.3 | 57.3 | 14.9 | 17.0 | |
| m-5h | 96.8 | 1.6 | 1.0 | 0.7 | 81.1 | 36.9 | 68.2 | 32.6 | |
| TIO-6 | m-1h | 0 | 97.5 | 2.5 | 0 | ND | 18.8 | 8.2 | ND |
| w-1h | 0 | 97.5 | 2.5 | 0 | ND | 19.3 | 4.2 | ND | |
| m-5h | 0.8 | 97.3 | 0.1 | 1.8 | 7.5 | 19.0 | 22.2 | 0.7 | |
| ST-G1 | m-1h | 0.9 | 97.6 | 0.2 | 1.3 | 20.7 | 87.1 | 46.3 | 71.7 |
| w-1h | 1.2 | 98.6 | 0.02 | 0.1 | 46.7 | 93.8 | ND | 74.1 | |
| m-5h | 0.2 | 98.1 | 0.9 | 0.9 | 20.0 | 95.5 | 51.4 | 3.6 | |
| TIO-5 | m-1h | 8.9 | 90.0 | 0 | 1.1 | 152.1 | 168.6 | 5.2 | 42.7 |
| w-1h | 4.3 | 94.2 | 0.1 | 1.5 | 147.1 | 157.2 | 58.3 | 13.3 | |
| m-5h | 8.9 | 89.2 | 0.8 | 1.1 | 169.5 | 197.6 | 36.8 | 66.6 | |
| Samples | Content (at %) | Cu/Ti | Ti 2p3/2 (%) | Cu 2p3/2 (%) | ||||||||
|---|---|---|---|---|---|---|---|---|---|---|---|---|
| C 1s | O 1s | Ti 2p3/2 | Cu 2p3/2 | Ti3+ | Ti4+ | Cu | Cu2O | CuO | Cu(OH)2 | |||
| P25 | bare | 47.1 | 39.7 | 13.2 | - | - | 0.5 | 99.5 | - | - | - | - |
| m-1h | 39.9 | 39.8 | 18.9 | 1.4 | 0.075 | 3.6 | 96.4 | 7.9 | 79.2 | 12.4 | 0.5 | |
| w-1h | 49.2 | 35.2 | 14.7 | 0.9 | 0.059 | 3.3 | 96.7 | 1.5 | 28.3 | 69.6 | 0.6 | |
| m-5h | 47.8 | 36.1 | 14.7 | 1.5 | 0.099 | 4.9 | 95.1 | 18.8 | 70.0 | 8.3 | 2.9 | |
| TIO-5 | bare | 47.0 | 40.1 | 12.9 | - | - | 1.4 | 98.6 | - | - | - | - |
| m-1h | 49.7 | 34.8 | 13.3 | 3.0 | 0.180 | 3.4 | 96.6 | 8.5 | 25.6 | 59.4 | 6.5 | |
| w-1h | 54.3 | 32.4 | 11.3 | 2.0 | 0.220 | 3.0 | 97.0 | 0.3 | 71.9 | 3.4 | 24.4 | |
| m-5h | 49.8 | 34.6 | 13.1 | 2.6 | 0.195 | 3.0 | 97.0 | 8.1 | 15.9 | 43.5 | 32.5 | |
Publisher’s Note: MDPI stays neutral with regard to jurisdictional claims in published maps and institutional affiliations. |
© 2020 by the authors. Licensee MDPI, Basel, Switzerland. This article is an open access article distributed under the terms and conditions of the Creative Commons Attribution (CC BY) license (http://creativecommons.org/licenses/by/4.0/).
Share and Cite
Endo-Kimura, M.; Karabiyik, B.; Wang, K.; Wei, Z.; Ohtani, B.; Markowska-Szczupak, A.; Kowalska, E. Vis-Responsive Copper-Modified Titania for Decomposition of Organic Compounds and Microorganisms. Catalysts 2020, 10, 1194. https://doi.org/10.3390/catal10101194
Endo-Kimura M, Karabiyik B, Wang K, Wei Z, Ohtani B, Markowska-Szczupak A, Kowalska E. Vis-Responsive Copper-Modified Titania for Decomposition of Organic Compounds and Microorganisms. Catalysts. 2020; 10(10):1194. https://doi.org/10.3390/catal10101194
Chicago/Turabian StyleEndo-Kimura, Maya, Bariş Karabiyik, Kunlei Wang, Zhishun Wei, Bunsho Ohtani, Agata Markowska-Szczupak, and Ewa Kowalska. 2020. "Vis-Responsive Copper-Modified Titania for Decomposition of Organic Compounds and Microorganisms" Catalysts 10, no. 10: 1194. https://doi.org/10.3390/catal10101194
APA StyleEndo-Kimura, M., Karabiyik, B., Wang, K., Wei, Z., Ohtani, B., Markowska-Szczupak, A., & Kowalska, E. (2020). Vis-Responsive Copper-Modified Titania for Decomposition of Organic Compounds and Microorganisms. Catalysts, 10(10), 1194. https://doi.org/10.3390/catal10101194

